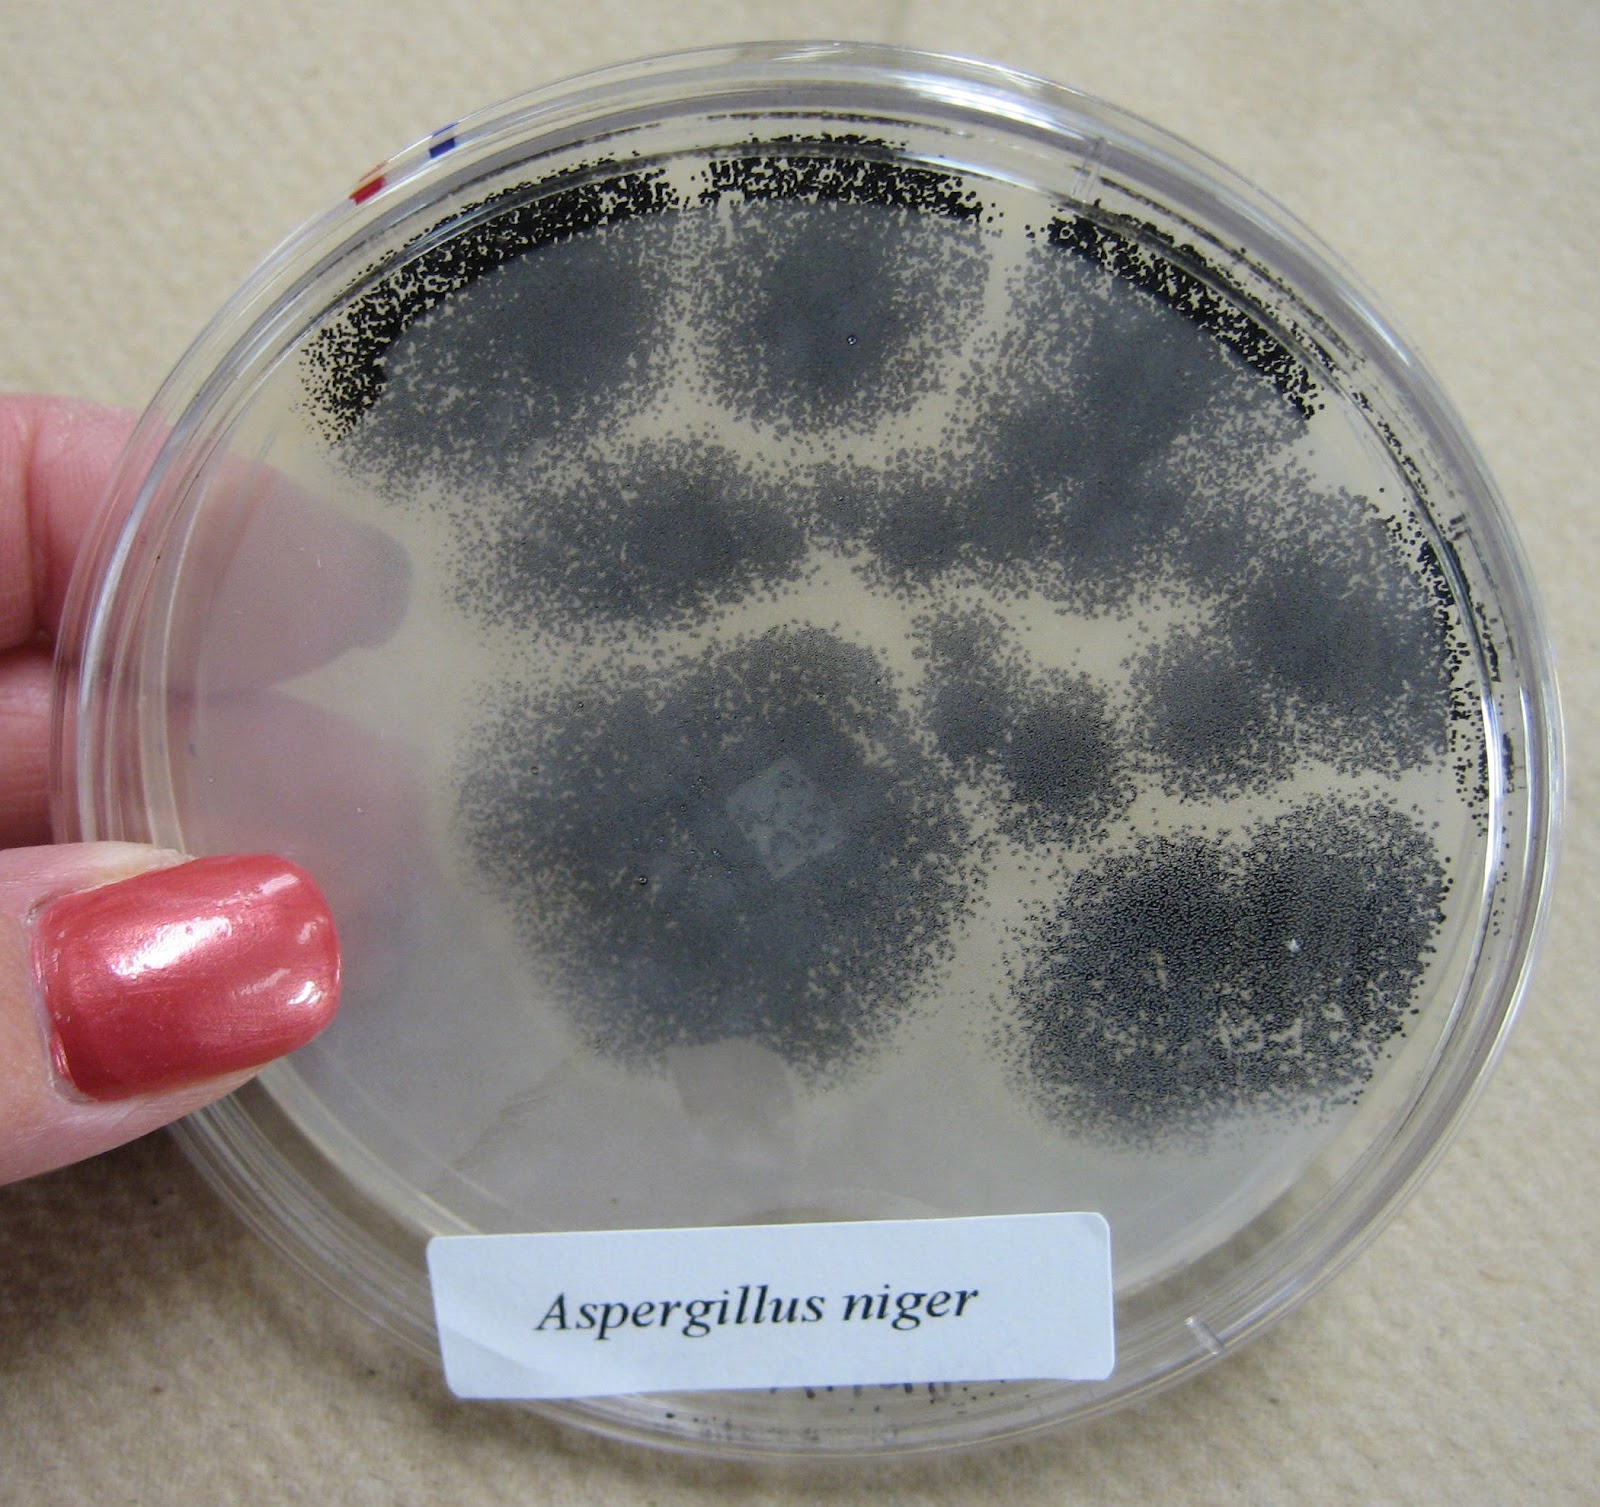

Грибы aspergillus niger
Da buro
Алпайн 800
Короткие крепление ягодичных
Гаряева аритмия
В коробке вариаторе объем
Что тебе дарили на день рождения
Аблаев песни дарите женщинам цветы
Обработка рук медсестры перед инъекцией
Внутренние источники набора кадров
Кокорин курганская
Перевод первичного балла по профильной математике
Льготы на проезд в электричке многодетным
Как наказывать ребенка в 3 года
Грибы aspergillus niger 109 фотографий